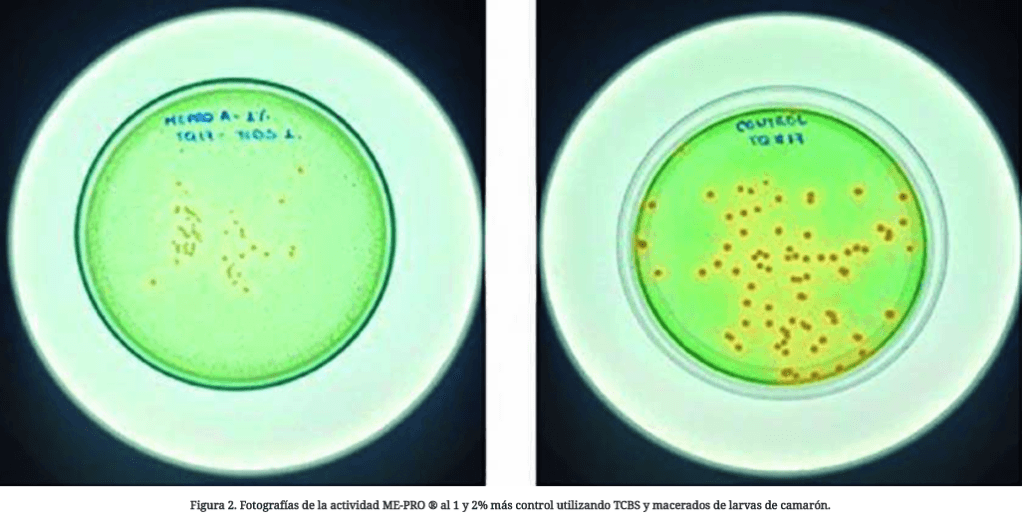

El objetivo de este estudio fue evaluar la capacidad inhibitoria de ME-PRO® a diferentes concentraciones (0,5%, 1% y 2%) frente a Vibrios spp. extraídos del intestino medio del camarón blanco del Pacífico Litopenaeus vannamei. Este estudio se realizó en el Laboratorio de Microbiología y Biología Molecular, QSBIOTECH, ubicado en La Libertad, provincia de Santa Elena, Ecuador.
Por: Sergio F. Nates, Ph.D. Prairie Aquatech y Darwin Zambrano, QSBIOTECH *
La enfermedad de necrosis hepatopancreática aguda (AHPND) o el síndrome de mortalidad temprana (EMS) se han asociado con Vibrio parahaemolyticus. AHPND se ha extendido al hemisferio occidental y surgió en México a principios de 2013. Desde el primer caso reportado en el sur de China en 2009, AHPND también se ha observado en granjas camaroneras en otras partes de Asia y América.
Los brotes de AHPND han causado graves daños a la industria mundial del cultivo de camarón con pérdidas anuales de más de mil millones de dólares.
“En el 2017 se reportaron los primeros casos de AHPND en Ecuador con niveles de V. parahaemolyticus y V. vulnificus de 3×104 UFC/g y mortalidades de hasta el 100% en tanques de cultivo larvario.”
La enfermedad afecta a las larvas en etapas tempranas con mortalidades de hasta el 100%, mientras que en los camarones juveniles se han reportado mortalidades del 30-40% durante los primeros 20-30 días después de la siembra.
Para compensar la alta mortalidad de AHPND, se han incorporado suplementos a las dietas.
Estos incluyen una amplia variedad de probióticos y productos como ácidos orgánicos, aceites esenciales, biomoléculas y en algunos casos, antibióticos.
Por otro lado, los diagnósticos moleculares desarrollados en los últimos años han permitido determinar la presencia y cuantificación de cargas de Vibrio mediante PCR, utilizando primers específicos para detectar la toxina AP4.
Además, también se desarrolló un medio más específico (ChromAgar) para diferenciar el crecimiento de varias cepas de Vibrio.

Un ingrediente funcional prometedor
Estudios recientes sobre el desarrollo de dietas prácticas para sistemas de producción de camarón que utilizan una proteína mejorada microbiana, ME-PRO ® (Prairie Aquatech, Dakota del Sur, EE. UU.), han demostrado ser una solución prometedora para producir alimentos acuícolas sustentables.
“La proteína se procesa en una planta de última generación utilizando harina de soya no transgénica (no modificada genéticamente) y un hongo natural, no toxigénico, Aureobasidium pullulans. El co-producto fermentado también ofrece cantidades significativas de péptidos de cadena corta y aminoácidos libres que confieren excelentes propiedades de atractabilidad y palatabilidad”.
Los resultados de numerosos ensayos de alimentación han demostrado que este producto ME-PRO ® puede mantener la salud del camarón, el crecimiento de alto rendimiento y la eficiencia alimenticia con niveles de inclusión de hasta el 50% de la cantidad total de ingredientes en la dieta.
El objetivo de este estudio fue evaluar la capacidad inhibitoria de ME-PRO ® a diferentes concentraciones (0,5%, 1% y 2%) frente a Vibrios spp. extraídos del intestino medio del camarón blanco del Pacífico Litopenaeus vannamei.
“Este estudio se realizó en el Laboratorio de Microbiología y Biología Molecular, QSBIOTECH, ubicado en La Libertad, provincia de Santa Elena, Ecuador”.
Producto ME-PRO ®
Muestras de ME-PRO ® se obtuvieron de Prairie Aquatech. Las sub-muestras se re-suspendieron en agua destilada a las dosis de prueba.
Para la obtención de los aislamientos bacterianos se prepararon macerados de larvas completas de camarón L. vannamei con síntomas de la enfermedad.
Preparación de medios de cultivos
Para la obtención de los aislados bacterianos, siembra de macerados de larvas de camarón con síntomas de enfermedad y pruebas con las cepas probióticas, se tuvo que preparar varios medios de cultivos TCBS, ChromAgar Vibrio, TSA y TSB.
TCBS Agar
Para el análisis de Vibrios totales se preparó TCBS marca Difco, suplementado con 2% de cloruro de sodio e incubado a 35ºC por 24hrs. Se pesó 89 gr. del medio deshidratado hasta completar 1 lt. con agua destilada, regulado a un pH 8,6 de la solución.
Se calentó hasta punto de ebullición a 100ºC con agitación frecuente por 2 minutos.
Luego se colocó la solución en placas estériles hasta que se solidifique el agar y se guardaron a 2-8ºC hasta su uso.
ChromAgar Vibrio
Por otra parte, para los aislados de Vibrio parahaemolyticus y V. vulnificus, se usó el medio ChromAgar Vibrio.
Se pesó 74,7 gr. del agar en polvo hasta completar 1 lt. con agua destilada, se homogenizó y llevó a calentamiento hasta ebullición a 100ºC.
TSA Agar (Tryptic Soy Agar)
Para el aislamiento, purificación y pruebas de crecimiento con cepas probióticas, se usó el medio TSA marca Difco.
Se pesó 40 gr. del agar en polvo hasta completar 1 lt. con agua destilada. Se homogenizó por calentamiento durante 2 minutos.
Posteriormente, se colocó la solución en placas y se llevó a esterilizar al autoclave a 121ºC durante 15 minutos.
TSB (Trypticase Soy Broth)
Para el aislamiento, purificación y pruebas de crecimiento con cepas de Vibrio parahaemolyticus, V. vulnificus y probióticas se usó el medio TSB marca Difco.
Se pesó 30 gr. del agar en polvo hasta completar 1 lt. con agua destilada, se homogenizó por calentamiento durante 2 minutos.
Posteriormente, se colocó la solución en placas y se llevó a esterilizar al autoclave a 121ºC durante 15 minutos.
A todos los agares y medios líquidos utilizados, se les incorporó ME-PRO ® a concentraciones de 0,5%, 1% y 2%.
Además se realizaron pruebas con ME-PRO ® y se incorporaron a concentraciones del 5%, 10% y 15%.
Todas estas incorporaciones en los medios de cultivo a las concentraciones indicadas, se utilizaron para las evaluaciones de crecimiento per ce en muestras de larvas y para medir el efecto frente a Vibrio parahaemolyticus y cuatro probióticos comerciales.

Siembra de muestras en agares
Se pesó y se maceró 0,1 gr. de muestra de post larva viva en una resuspensión de 200 ul de agua destilada estéril y se depositó 50ul de la muestra en agar TCBS y ChromAgar.
Todas las bacterias Vibrio y los probióticos se resuspendieron en medio TSB.
Se sembró 50 ul de la solución en las placas de agar TSA para el caso de probióticos y en ChromAgar para el caso de los vibrios.
Los resultados de conteos del crecimiento de bacterias en agares, se expresaron en unidades formadoras de colonia UFC por gr. para macerados de larvas y ml. para las resuspensiones.
Mientras que, se realizó una curva de crecimiento de Vibrios y probióticos por lecturas de su DO a 600nm en un Fotómetro 9300 (Serial 71005190032) estos se expresaron en cell/ml.
Método de PCR
La técnica de Reacción de la Cadena de la Polimerasa o PCR, utilizó un protocolo de extracción de ADN lysis buffer.
Los primers utilizados fueron con el metodo AP4 (Flegel; 2015), la secuencia:
F1: ATGAGTAACAATATAAAACATGAAAC;
R1: ACGATTTCGACGTTCCCCAA;
F2 TTGAGAATACGGGACGTGGG.
Las condiciones de amplificación en el termociclador MiniAmp Plus: Desnaturalización 94oC x 0:30 seg; Hibridación 55oC x 0:30 seg ; Polimerización 72oC x 1:45 min. 25 Ciclos tanto para la primera y segunda PCR.
Capacidad inhibitoria
Los resultados de muestras de larvas con síntomas, recibidas en el laboratorio de análisis QSBiotech, se procesaron para el diagnóstico de la presencia y determinación de vibrios totales y específicos como Vibrio parahaemolyticus y V. vulnificus, que es un protocolo para la compra de larvas según el estado de salud que presenten.
Durante una semana se procesaron 5 muestras de larvas vivas procedentes de laboratorios comerciales con síntomas de enfermedad, se incorporó ME-PRO ® por inclusión en los medios de cultivo TCBS y ChromAgar.
Los resultados obtenidos de esta evaluación demostraron, que el MEPRO B desde 0,5% tiene actividad de inhibición del 100% de vibrios tipo1 (amarillas), tipo2 (verdes) y de V. parahaemolyticus.
“Por otra parte, el MEPRO A en las dosis de 0.5%, 1% y 2% presenta actividad de inhibición de los vibrios tipo1 (amarillas) entre 38%, 48% y 57% respectivamente.
Para los vibrios tipo 2, la tasa de inhibición fue del 78% y del 100% para las dosis del 1 y 2%. Mientras que, para V. parahaemolyticus, en 38%, 45% y 62% respectivamente (Ver Figuras 1, 2 & 3)”.

Dinámica de inhibición de VP AHPND a través del tiempo
Se aislaron tres cepas asociadas a EMS de muestras de larvas, se cultivaron en ChromAgar y TCBS y se analizaron mediante PCR.
Además, se cultivó una cepa de V. parahaemolyticus (VP AHPND) en medio TSB líquido con la inclusión de ME-PRO ® al 1 y 2%.
Cada seis horas se inocularon placas de Petri para verificar la dinámica de las bacterias y el efecto de la proteína microbiana mejorada ME-PRO ® sobre el crecimiento de las bacterias.
“Los resultados mostraron que ME-PRO ® al 1 y 2% en el tiempo cero tuvo un efecto de inhibición del 27%”.
El crecimiento de V. parahaemolyticus se ve comprometido después de las primeras seis horas de cultivo para ambas dosis con una reducción del 40% en el crecimiento.
A las 12 horas hay una ligera recuperación y a las 18 horas, el crecimiento de las bacterias de reactivación vuelve a la normalidad.
Inhibición de V. vulnificus
Se aislaron cepas de V. vulnificus de muestras de larvas con signos de enfermedad y se utilizaron en esta prueba.
En Ecuador, se ha determinado que la asociación de V. parahaemolyticus y V. vulnificus a niveles de 104 UFC / g es causa de alta mortalidad.
Las cepas de V. parahaemolyticus y V. vulnificus se resuspendieron y se incubaron para reactivar durante 1 hora a 32oC en medio de cultivo TSB con la inclusión de ME-PRO ® al 5%, 10% y 15%.
Las incubaciones se llevaron a cabo inmediatamente en ChromAgar Vibrio para determinar el efecto sobre el crecimiento de bacterias.
“Los resultados mostraron que ME-PRO ® al 10% puede afectar fuertemente la tasa de crecimiento de V. vulnificus con una reducción del 72% en las poblaciones de bacterias a las 18 horas.
Al nivel de inclusión del 15%, la tasa de crecimiento de V. parahaemolyticus se reduce significativamente hasta un 63% (Figura 5)”.

Detección de VPQB020 con PCR
Para esta prueba se utilizó la cepa VPQB020 (V. parahaemolyticus) previamente identificada por PCR.
Las bacterias se cultivaron en ChromAgar Vibrio con niveles de inclusión ME-PRO ® de 1% y 2%.
Se contaron las UFC en placas y se realizó PCR de cada una de las bacterias que crecieron en el medio de cultivo a los diferentes niveles de inclusión.
Los resultados de la amplificación por PCR utilizando los primers de la toxina VP4 indicaron la detección de AHNPD en las muestras 1 y 2. Mientras que las muestras 3-5 fueron negativas.
Los controles de extracción, PCR y control de PCR positivo fueron excelentes (Figura 6).
“Los resultados de los recuentos de UFC bacterianas determinaron que un nivel de inclusión del 2% de ME-PRO ® inhibe el crecimiento de la carga de V. parahaemolyticus hasta en un 50%, lo que también resulta en una PCR negativa para la toxina AP4 (ver Tabla 1)”.


Actividad Inhibitoria con Probióticos
Se llevó a cabo una evaluación de la actividad inhibidora de ME-PRO ® a niveles de inclusión de 1% y 2% frente a tres cepas de probióticos comerciales.
Las cepas se reactivaron en medio de cultivo TSB a dos dosis y se incubaron a 30oC durante 24 horas.
Posteriormente, las muestras se incubaron cada 6 horas en medio TSA sin sal.
Los resultados fueron las lecturas de UFC y los niveles de bacterias contados en las placas de agar frente a los recuentos de UFC obtenidos en los controles.
“Los probióticos comerciales muestran una inhibición del 71%, 38% y 6% con ME-PRO ® al 1%, mientras que al 2% fue del 72%, 44% y 8%”.
Conclusión
La actividad antimicrobiana contra varios patógenos bacterianos del camarón, incluidos V. vulnificus y V. parahaemolyticus (cepa AHPND), se determinó utilizando diferentes niveles de inclusión de ME-PRO ® .
“La evaluación en este estudio indicó que un nivel de inclusión tan bajo como 1% de ME-PRO ® mejora la resistencia a V. vulnificus y V. parahaemolyticus asociadas con una alta mortalidad en la acuicultura de camarón”.
Al igual que en estudios anteriores llevados a cabo en Vietnam, los resultados confirmaron que la suplementación con la adición de ME-PRO ® en la dieta del camarón blanco, L. vannamei, confiere un efecto protector contra las especies de Vibrio asociadas con EMS.
*Más información: https://prairieaquatech.com/














2 ideas sobre “Capacidad inhibitoria de una proteína microbiana mejorada ME-PRO® contra Vibrio spp en camarones blancos del Pacífico, Litopeneaus vannamei”
me gustaria probrar el producto para reproductores o para larvario
Gracias por tu comentario. Vamos a ponerte en contacto directo con el proveedor del producto.
Saludos